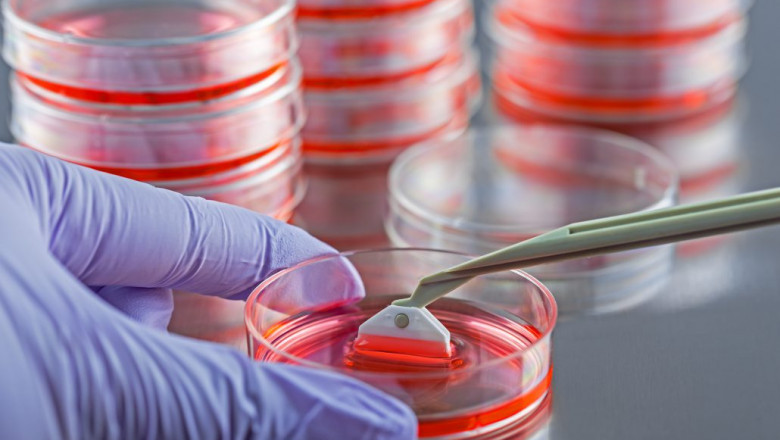

views
The growing prevalence of chronic diseases is propelling the global tissue transplantation market forward. According to the study 'Risk Factors and Rate of Progression of CKD in Children,' published in Kidney International Reports in June 2019, 38 percent of children had chronic kidney disease progression within two years of follow-up.
Furthermore, the increased frequency of cancer is likely to help the global tissue transplantation market's expansion over the forecast period. For example, the Leukemia and Lymphoma Society estimates that 176,200 persons in the United States will be diagnosed with leukaemia, lymphoma, or myeloma in 2019.
Read More: https://bloggerstrive.blogspot.com/2022/01/global-tissue-transplantation-market.html
Click here for Tissue Transplantation Products and Services Market Report: https://www.coherentmarketinsights.com/market-insight/tissue-transplantation-products-and-services-market-76